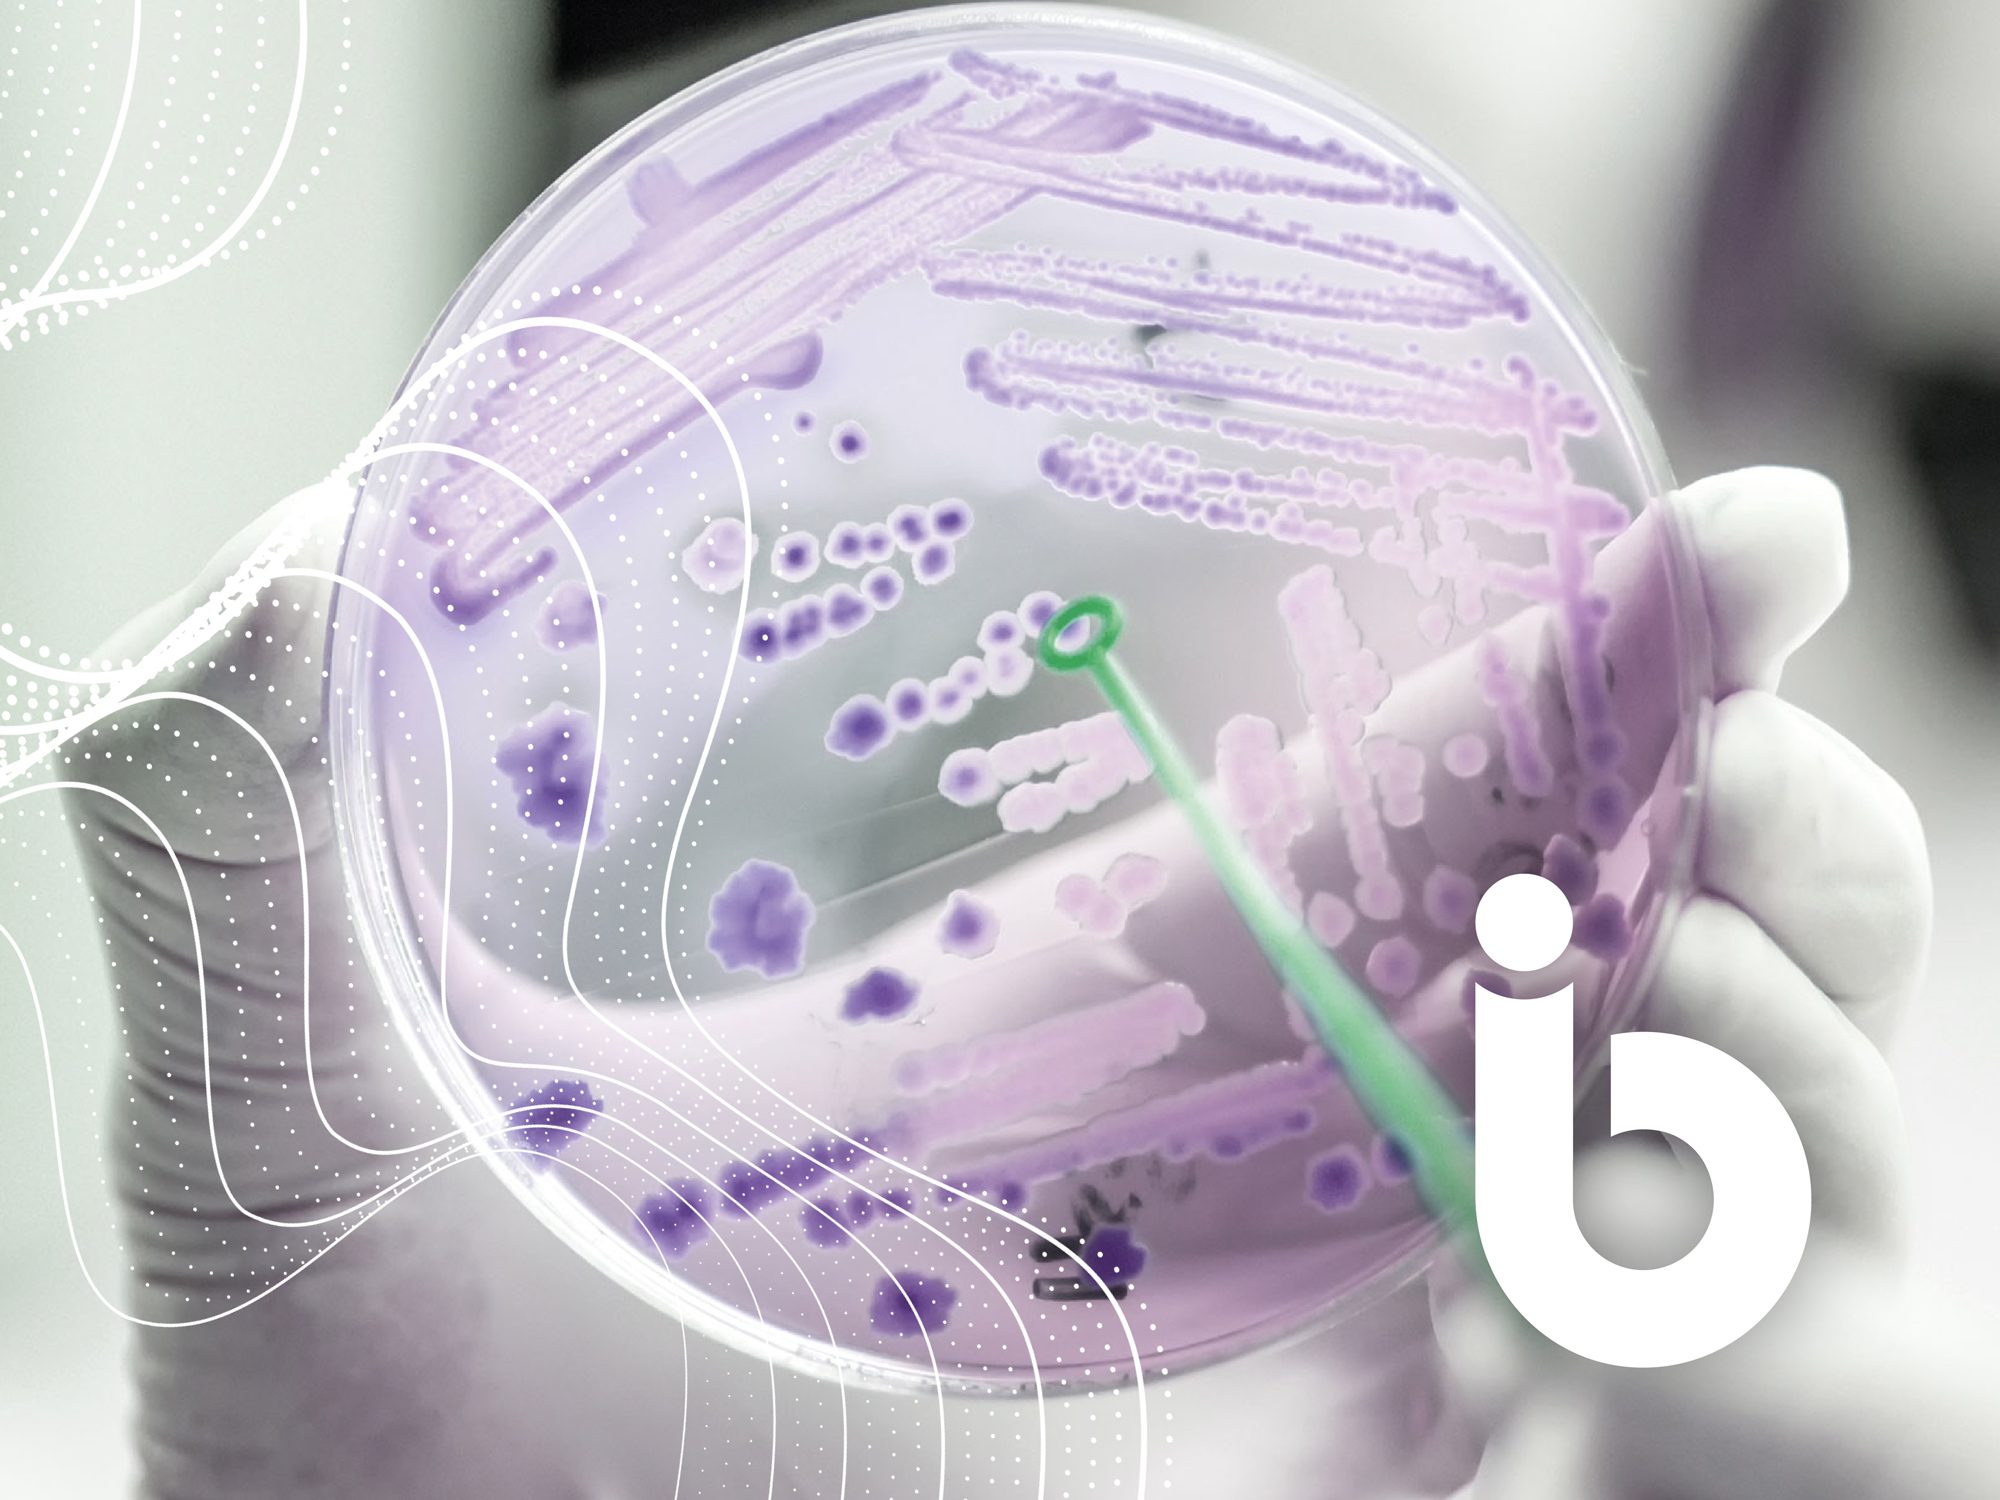

Raising Awareness with NBIC
LATEST NEWS
Shining a light on the challenges that biofilms present with an awareness campaign for NBIC

IDENTITY
#AwareWithFlare
The National Biofilms Innovation Centre are an Innovation Knowledge Centre (IKC), catalysing innovation in technologies and solutions to solve the challenges that biofilms present to industry.
Having established a close relationship with NBIC, modernising their brand identity and developing their contemporary website design, Identity Creative were brought on board to design their latest marketing campaign.
The #BiofilmAware campaign has been designed as a sub-brand in-line with NBIC brand guidelines to establish a consistent and recognisable presence. As well as working on the branding for the campaign, Identity Creative designed a range of social media templates that make use of the #BiofilmAware brand identity through colour, brand assets and imagery. A campaign guide that outlines the information people need to support NBIC in delivering the campaign, has also been designed by our team. As this year-long campaign continues we look forward to working with NBIC and developing further resources for the #BiofilmAware marketing.




